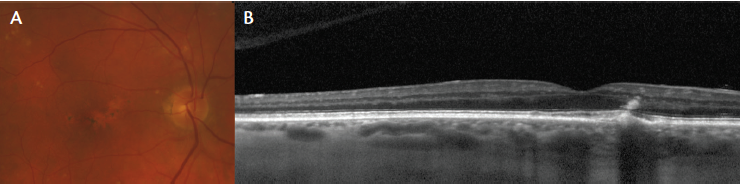

The term pachychoroid originates from the Greek παχύ, or pachy, which means thick. The term was introduced in a paper by Warrow and colleagues describing eyes with pigmentary changes resembling those often seen in the fellow eyes of patients with unilateral central serous chorioretinopathy (CSC).1 In that paper, this entity was referred to as pachychoroid pigment epitheliopathy (PPE).1 Although these eyes had many of the choroidal features seen in CSC, the pigmentary changes appeared to occur in the absence of subretinal fluid.1 Pang and Freund observed that patients with PPE were often misdiagnosed as having early or atypical age-related macular degeneration (AMD), pattern dystrophy, or inflammatory disease of the retinal pigment epithelium (RPE) including acute retinal pigment epitheliitis and punctate inner choroidopathy.2 Consequently, they stressed the importance of recognizing the characteristic choroidal changes that help establish this diagnosis.
AT A GLANCE
• The pachychoroid clinical spectrum is a group of macular diseases that manifest similar choroidal findings.
• CSC, pachychoroid pigment epitheliopathy, pachychoroid neovasculopathy, and PCV are entities of the pachychoroid clinical spectrum.
• Further research is needed to understand what causes these choroidal abnormalities and how they relate to the entities in this spectrum of macular disease
Subsequent reports note that a wider range of disease entities manifest choroidal findings similar to those seen in PPE.3-5 This observation was used to justify including these disorders in a group of macular diseases referred to as the pachychoroid clinical spectrum. The definition of the pachychoroid phenotype continues to evolve with the application of novel multimodal imaging techniques. This article describes the entities that comprise the pachychoroid spectrum.
CENTRAL SEROUS CHORIORETINOPATHY
CSC, formerly known as central serous retinopathy, is best recognized in terms of idiopathic noninflammatory serous macular detachment, with or without serous pigment epithelial detachment (PED). Acute CSC is more common in men than in women, and it typically occurs in the fourth and fifth decades of life. Bilateral involvement is frequent, and some cases of CSC are associated with elevated levels of circulating corticosteroids. Fluorescein angiography (FA) typically shows focal leakage at the level of the RPE filling into a serous subretinal compartment. Well-defined serous PED may also be detected.4,6
Although acute CSC is usually self-limited, chronic or recurrent CSC can persist beyond the sixth and seventh decades with atrophic and/or neovascular sequelae.5 Progressive pathologic changes in the RPE result in ill-defined leakage that may be difficult to distinguish from diffuse window defects.

Figure 1. Chronic CSC in a 69-year-old woman. The color photograph (A) and fundus autofluorescence image (B) show RPE changes. The en face OCT (C) and choroidal thickness map (D) show increased choroidal thickness in the area of RPE changes that corresponds with the presence of pachyvessels. The OCT scan (E) demonstrates subretinal fluid.
In eyes with CSC, indocyanine green angiography (ICGA) typically shows dilated choroidal vessels that are diagonally oriented and that communicate with the vortex ampullae. In areas where FA shows leakage at the level of the RPE, ICGA shows choroidal hyperpermeability. In addition to demonstrating retinal detachment and PED, cross-sectional optical coherence tomography (OCT) shows increased (≥ 300 µm) choroidal thickness and localizes the dilated vessels seen on ICGA to the outer choroid.
For convenience, we refer to these dilated vessels as pachyvessels, and we have found them to be characterized not only by their intrinsic state of distension but also by a degree of choriocapillaris and Sattler layer attenuation occurring at the inner aspect of the choroid (Figure 1).
PACHYCHOROID PIGMENT EPITHELIOPATHY

Figure 2. PPE in a 25-year-old woman. The color photograph (A) and ICGA (B) demonstrate focal juxtafoveal RPE changes overlying an area of dilated choroidal vessels (pachyvessels). En face OCT (C) and structural OCT (D) scans show pachyvessels associated with choriocapillaris compression with overlying RPE disruption.
As described above, PPE may represent a forme fruste of CSC. Although usually bilateral, CSC can occur asymmetrically.1,2 In many cases examination of the apparently uninvolved fellow eyes of patients manifesting unilateral subretinal fluid reveals nonspecific RPE changes. In our group’s original description of PPE, we reported that similar RPE changes may also be observed in patients without a known history of CSC or evidence of prior subretinal fluid on multimodal imaging. Fundus autofluorescence imaging of these areas of retinal pigment epitheliopathy may show foci of both hyperautofluorescence and hypoautofluorescence. Cross-sectional OCT through hyperautofluorescent foci shows pigment epithelial hyperplasia. The choroid is also characteristically thick in areas of pigment epitheliopathy, and the increased thickness is accounted for by pachyvessels with overlying attenuation of the choriocapillaris and Sattler layers. The pachyvessels, therefore, run in close proximity to the RPE-Bruch membrane complex, suggesting that they are mechanistically involved in inciting pigment epitheliopathy (Figure 2).
PACHYCHOROID NEOVASCULOPATHY
Neovascularization is a recognized complication of CSC. Although type 2 and type 3 neovascularization have been reported, type 1 neovascularization is seen most frequently in this setting.3,5 Type 1 neovascularization can also occur in a number of other macular diseases, most notably in AMD.
Pachychoroid neovasculopathy (PNV) is distinguished from neovascular AMD by several features, including younger age at onset of neovascularization, a relative absence of drusen, and a thick choroid with pachyvessels. Although elderly patients can exhibit clinical features of both PNV and neovascular AMD, in an overlapping phenotype, a substantial number of patients do present in their 50s and 60s with well-defined pachychoroid characteristics and absent drusen. By contrast, the occurrence of type 1 neovascularization in the absence of drusen is uncommon in AMD.7
Type 1 neovascularization in AMD is recognized with retinal imaging on the basis of ill-defined hyperfluorescence on FA and/or late leakage of indeterminate origin with a corresponding PED on cross-sectional structural OCT. Subretinal fluid and/or subretinal hyperreflective exudation adjacent to the PED is considered a sign of active neovascularization (Figure 3). On the one hand, interpretation of these signs in CSC can be confounded by atrophic RPE window defects, diffuse leakage at the level of the RPE due to CSC, and subretinal fluid attributable to CSC. Thus, OCT angiography (OCTA) may be more sensitive for the detection of the vascular network compared with FA images (Figure 4). On the other hand, type 1 neovascularization in the pachychoroid setting often takes the form of a shallow irregular PED, which appears as a double layer sign on structural OCT, and which has been shown retrospectively to be predictive of neovascularization.8

Figure 3. PNV in a 54-year-old woman. The color photograph (A) and en face OCT image (B) show RPE changes overlying an area of pachyvessels. The FA (C) and ICGA (D) show mild window defects and staining in the area of RPE changes with associated choroidal hyperpermeability. The OCT scan (E) shows a shallow PED with overlying subretinal fluid.

Figure 4. PNV in an 85-year-old man. The color photograph (A) and fundus autofluorescence image (B) demonstrate diffuse RPE changes with an area of RPE atrophy. The FA and a corresponding area (C, yellow square) imaged with OCTA (D) show the presence of neovascular tissue that is more clearly delineated with OCTA. The FA shows early hyperfluorescence in the area of RPE changes. The OCT scan (E) shows a pachychoroid with the presence of pachyvessels and choriocapillaris compression. There is an overlying shallow PED associated with subretinal fluid.
POLYPOIDAL CHOROIDAL VASCULOPATHY
Polypoidal choroidal vasculopathy (PCV) was first described by Yannuzzi and associates as a vasculopathy located in the inner choroid and visualized best with ICGA.9 Cross-sectional imaging with OCT localizes these lesions and their branching vascular networks to the sub-RPE space anterior to the Bruch membrane.
Although the anatomic location classifies polypoidal disease as a form of type 1 neovascularization, a number of questions remain unanswered concerning its etiology. PCV has a predilection for patients of Asian or African ancestry, although it also occurs in white individuals. In the absence of an understanding of its mechanism of action, PCV has traditionally been considered either a standalone idiopathic entity or a variant of neovascular AMD. However, closer examination of the choroids of many patients diagnosed with PCV reveals features consistent with those of the pachychoroid phenotype: minimal or absent drusen, thicker choroids than are typical for AMD, pachyvessels with inner choroid attenuation, and shallow irregular PEDs. PCV has even been described as masquerading as CSC (Figure 5).9,10

Figure 5. PCV in a 63-year-old woman. Lipid exudates are seen on the color photograph of the superonasal macula (A). ICGA (B) shows multiple polyps that overly pachyvessels on the corresponding OCT scan (C).
Figure 6. PPE in an 85-year-old man showing reduced fundus tessellation related to the presence of a thick choroid (A). Focal RPE changes are seen on the OCT scan (B).
REDUCED FUNDUS TESSELLATION
In addition to the multimodal imaging features described above, eyes with pachychoroid spectrum disease typically exhibit reduced fundus tessellation at the posterior pole when examined clinically or with color or red-free photography. The reason for reduced visualization of choroidal features through the RPE may be due to changes in choroidal pigmentation or to choroidal thickening. However, where the inner choroid is attenuated and the pachyvessels course along the outer aspect of the Bruch membrane, they may be visualized directly or they may incite RPE hyperplasia. Recognition of these features can raise a clinician’s suspicion for a pachychoroid-related diagnosis (Figure 6).11
CONCLUSION
Pachychoroid diseases benefit from a multimodal imaging approach, to avoid misdiagnosis as other conditions including AMD, pattern dystrophy, punctate inner choroidopathy, and retinal pigment epitheliitis. The spectrum of pachychoroid disorders is characterized by three main tomographic features: increased choroidal thickness (diffuse or focal), dilation of outer choroidal vessels (thus called pachyvessels), and attenuation and thinning of the choriocapillaris and the middle choroidal vessels (Sattler layer) overlying these pachyvessels. The use of OCTA in association with high-penetrance OCT scans and en face structural OCT may lead to early detection of shallow type 1 neovascularization that may form a branching vascular network from which polypoidal lesions may originate.
Characteristically, PPE and CSC are diagnosed in a patient in his or her early 30s or 40s. Over time, both diseases may lead to the development of a type 1 neovascularization (PNV), which in some eyes may progress to PCV with the presence of polypoidal lesions.3 Thus, these entities appear to share choroidal features that characterize the pachychoroid clinical spectrum. Much more work will be necessary to understand what produces these choroidal abnormalities and precisely how they relate to the various entities included in this spectrum of macular disease. n
1. Warrow DJ, Hoang QV, Freund KB. Pachychoroid pigment epitheliopathy. Retina. 2013;33(8):1659-1672.
2. Pang CE, Freund KB. Pachychoroid pigment epitheliopathy may masquerade as acute retinal pigment epitheliitis. Invest Ophthalmol Vis Sci. 2014;3(4):111-115.
3. Pang CE, Freund KB. Pachychoroid neovasculopathy. Retina. 2015;35(1):1-9.
4. Gallego-Pinazo R, Dolz-Marco R, Gómez-Ulla F, et al. Pachychoroid diseases of the macula. Med Hypothesis Discov Innov Ophthalmol. 2014;3(4):111-115.
5. Fung AT, Yannuzzi LA, Freund KB. Type 1 (sub-retinal pigment epithelial) neovascularization in central serous chorioretinopathy masquerading as neovascular age-related macular degeneration. Retina. 2012;32(9):1829-1837.
6. Dansingani KK, Balaratnasingam C, Naysan J, Freund KB. En face imaging of pachychoroid spectrum disorders with swept-source optical coherence tomography. Retina. 2016;36(3):499-516.
7. Dansingani KK, Balaratnasingam C, Klufas MA, et al. Optical coherence tomography angiography of shallow irregular pigment epithelial detachments in pachychoroid spectrum disease. Am J Ophthalmol. 2015;160(6):1243-1254.
8. Sato T, Kishi S, Watanabe G, et al. Tomographic features of branching vascular networks in polypoidal choroidal vasculopathy. Retina. 2007;27(5):589-594.
9. Yannuzzi LA, Sorenson J, Spaide RF, Lipson B. Idiopathic polypoidal choroidal vasculopathy (IPCV). Retina. 1990;10(1):1-8.
10. Yannuzzi LA, Freund KB, Goldbaum M, et al. Polypoidal choroidal vasculopathy masquerading as central serous chorioretinopathy. Ophthalmology. 2000;107(4):767-777.
11. Yan YN, Wang YX, Xu L, et al. Fundus tessellation: prevalence and associated factors: the Beijing Eye Study 2011. Ophthalmology. 2015;122(9):1873-1880.
Kunal K. Dansingani, MA, FRCOphth
• assistant professor, ophthalmology and visual sciences, Truhlsen Eye Institute, University of Nebraska Medical Center, in Omaha, Nebr.
• financial interest: none acknowledged
• kkd@doctor.com
Rosa Dolz-Marco, MD, PhD
• international fellow at Vitreous Retina Macula Consultants of New York and junior researcher at Unit of Macula, Institute of Health Research, University and Polytechnic Hospital La Fe in Valencia, Spain
• financial disclosure: research grants from Alcon, Allergan, Bayer, Heidelberg Engineering, Novartis, and Roche
• rosadolzmarco@gmail.com
K. Bailey Freund, MD
• retina specialist at Vitreous Retina Macula Consultants of New York; clinical professor of ophthalmology at the New York University School of Medicine; staff at New York Presbyterian Hospital, Manhattan Eye Ear & Throat Hospital, and Lenox Hill Hospital
• financial disclosure: consultant to Optovue, Heidelberg Engineering, and Optos
• kbfnyf@aol.com





















